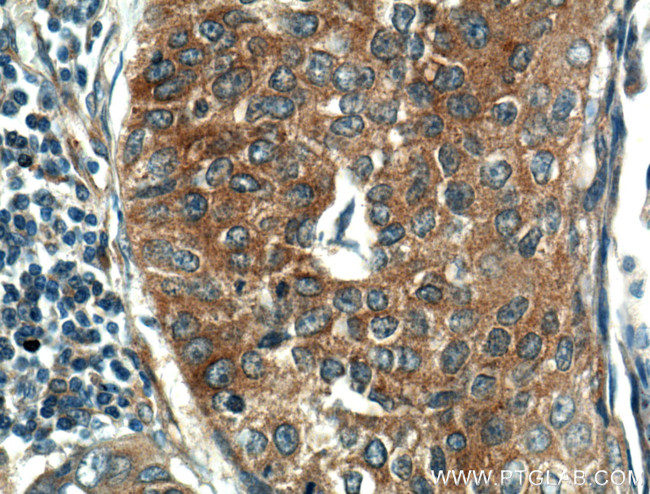
KEAP1 Antibody in Immunohistochemistry (Paraffin) (IHC (P))

Search
Proteintech
KEAP1 Polyclonal Antibody
{{$productOrderCtrl.translations['antibody.pdp.commerceCard.promotion.promotions']}}
{{$productOrderCtrl.translations['antibody.pdp.commerceCard.promotion.viewpromo']}}
{{$productOrderCtrl.translations['antibody.pdp.commerceCard.promotion.promocode']}}: {{promo.promoCode}} {{promo.promoTitle}} {{promo.promoDescription}}. {{$productOrderCtrl.translations['antibody.pdp.commerceCard.promotion.learnmore']}}
产品信息
10503-2-AP
种属反应
已发表种属
宿主/亚型
分类
类型
抗原
偶联物
形式
浓度
规格
纯化类型
保存液
内含物
保存条件
运输条件
产品详细信息
This antibody is a rabbit polyclonal antibody raised against residues near the C terminus of human KEAP1.
Immunogen sequence: GRLIYTAGG YFRQSLSYLE AYNPSDGTWL RLADLQVPRS GLAGCVVGGL LYAVGGRNNS PDGNTDSSAL DCYNPMTNQW SPCAPMSVPR NRIGVGVIDG HIYAVGGSHG CIHHNSVERY EPERDEWHLV APMLTRRIGV GVAVLNRLLY AVGGFDGTNR LNSAECYYPE RNEWRMITAM NTIRSGAGVC VLHNCIYAAG GYDGQDQLNS VERYDVETET WTFVAPMKHR RSALGITVHQ GRIYVLGGYD GHTFLDSVEC YDPDTDTWSE VTRMTSGRSG VGVAVTMEPC RKQIDQQNCT C (325-624 aa encoded by BC002930)
靶标信息
This gene encodes a protein containing KELCH-1 like domains, as well as a BTB/POZ domain. Kelch-like ECH-associated protein 1 interacts with NF-E2-related factor 2 in a redox-sensitive manner and the dissociation of the proteins in the cytoplasm is followed by transportation of NF-E2-related factor 2 to the nucleus. This interaction results in the expression of the catalytic subunit of gamma-glutamylcysteine synthetase. Two alternatively spliced transcript variants encoding the same isoform have been found for this gene.
仅用于科研。不用于诊断过程。未经明确授权不得转售。
生物信息学
蛋白别名: Cytosolic inhibitor of Nrf2; INRF2; KEAP1 delta C; Kelch-like ECH-associated protein 1; kelch-like family member 19; Kelch-like protein 19; KIAA0132; NRF2 cytosolic inhibitor; ring canal protein; unnamed protein product
基因别名: INRF2; KEAP1; KIAA0132; KLHL19; mKIAA0132
UniProt ID: (Human) Q14145, (Mouse) Q9Z2X8
Entrez Gene ID: (Human) 9817, (Mouse) 50868, (Rat) 117519